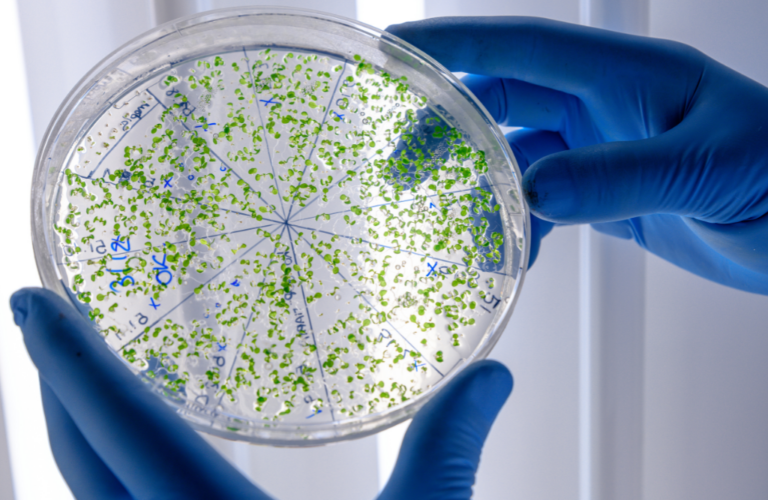

Learn Practical Skills Online from Top Medical Professionals
Improve Your Laboratory Skills with Courses and Certificates from Industry Leaders in Medical Laboratory Science.


2,000+
45+
2
15%
OUR MISSION
At E-Lab Academy, our mission is to elevate medical laboratory training in Africa by providing accessible, high-quality training to aspiring and current laboratory professionals. We are committed to advancing practical skills, diagnostic proficiency, and healthcare standards across developing and underserved regions. Through expert-led courses, innovative learning tools, and partnerships with industry leaders, we empower individuals and institutions to deliver more accurate and impactful healthcare solutions.
OUR VISION
Our vision is to be the leading platform for medical laboratory education and diagnostics, transforming healthcare by bridging knowledge gaps and promoting excellence in laboratory science. E-Lab Academy envisions a world where every laboratory professional is equipped with the skills, technology, and expertise needed to contribute effectively to global healthcare outcomes, ensuring quality diagnostics and better patient care for all.




Partner with Us to Transform Healthcare
Your support can help us expand access to vital training, reach underserved areas, and improve diagnostic accuracy on a global scale. Your grants will help fund training modules, expand platform capabilities, and produce high-quality learning resources. We have trained over 1,000 Medical laboratory practitioners, who now serve remote areas with improved diagnostic tools.
FROM SOME OF OUR STUDENTS
“E-Lab Academy has completely transformed my understanding of medical laboratory science! The interactive modules and hands-on virtual labs helped me build real-world skills I can confidently apply in any lab setting.“
Anita Morenikeji
“The courses are incredibly detailed yet easy to follow, even for beginners like me. E-Lab Academy made it possible for me to learn at my own pace without compromising on quality.”
Judas Okechukwu
“As a practicing lab scientist, E-Lab Academy has been invaluable in staying up-to-date with advancements in diagnostics. The platform’s expert-led courses and advanced training resources have improved my confidence in delivering accurate test results.”
Christabel Okaette
Latest Updates from E-Lab Academy
Certificates awarded to various batches of Medical Laboratory Science students who completed our intensive training programs. Having practical knowledge and direction from top experts, they are now better equipped with the practical skills needed to excel in the medical laboratory field.
Instructors Perspectives: The Importance of Our Medical Laboratory Academy
Welcome to our Instructors Perspective video series, where high-achieving scholars share their insights on the significance of improving medical laboratory practical skills through our Academy.
E-LAB ACADEMY CERTIFICATION
Demonstrate your new skills and gain a step up in your career with E-Lab Academy Recognized Certificate of completion.

OUR MEDICAL LABORATORY PRACTICAL COURSES
Practical based online courses
HOW IT WORKS
Registration
Create your account using a valid email address
Secure Payment
Contact our support for verification & Proceed with payment
Enrollment Confirmation
Complete your enrollment, receive instant access and start learning.
Get in Touch with E-Lab Academy
Whether you’re a student, medical professional, or potential partner, we’re here to help you get the information you need.
Reach out to us with any questions about our courses, programs, or partnership opportunities. We’re committed to advancing medical laboratory education and diagnostics together.
Phone: +234 708 095 9768
Email: info@elabacademy.com
Grants & Partnerships: grants@elabacademy.org
Send us a direct message
Ready to Elevate Your Medical Lab Skills?
Join thousands of aspiring and experienced medical laboratory professionals who have chosen E-Lab Academy to advance their careers.